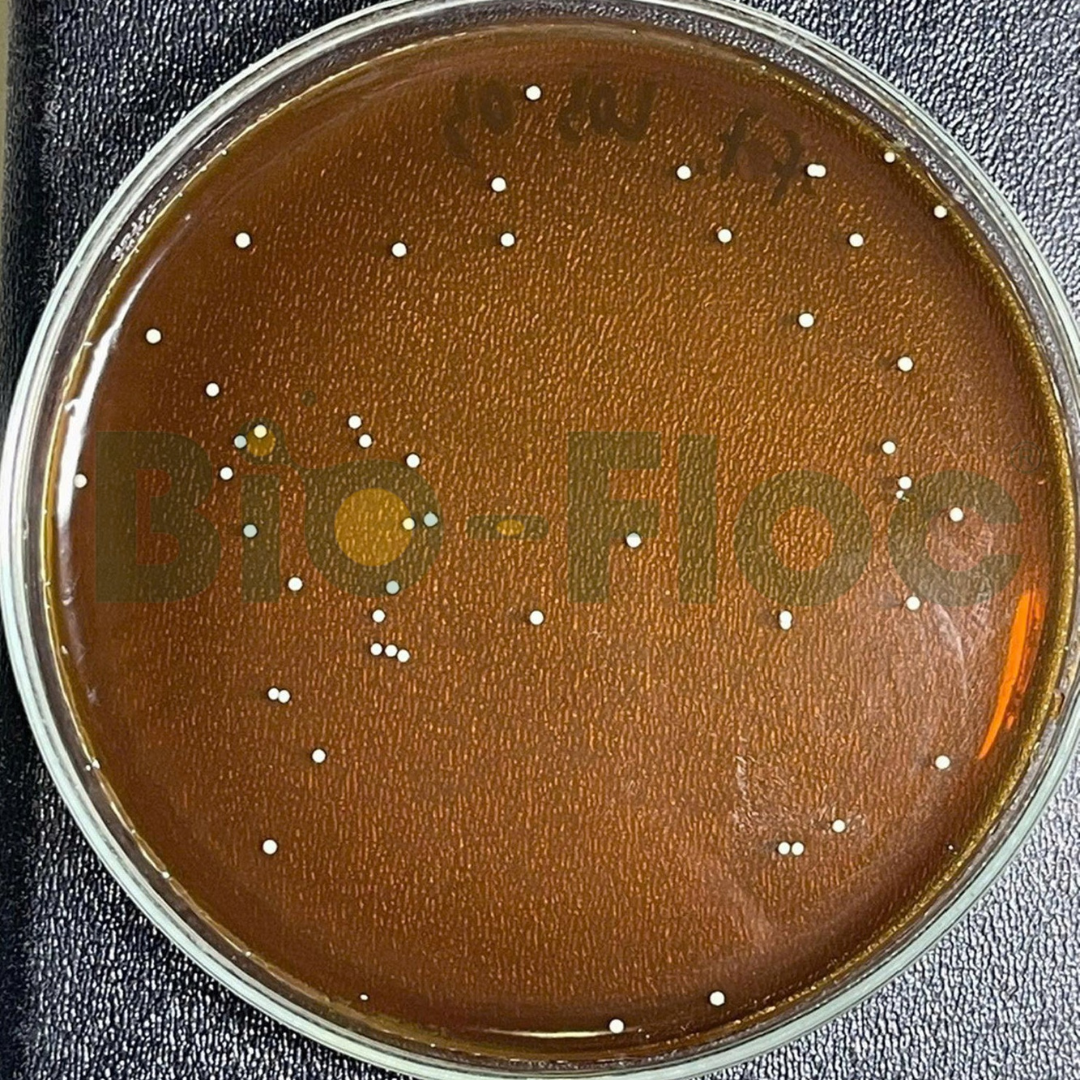
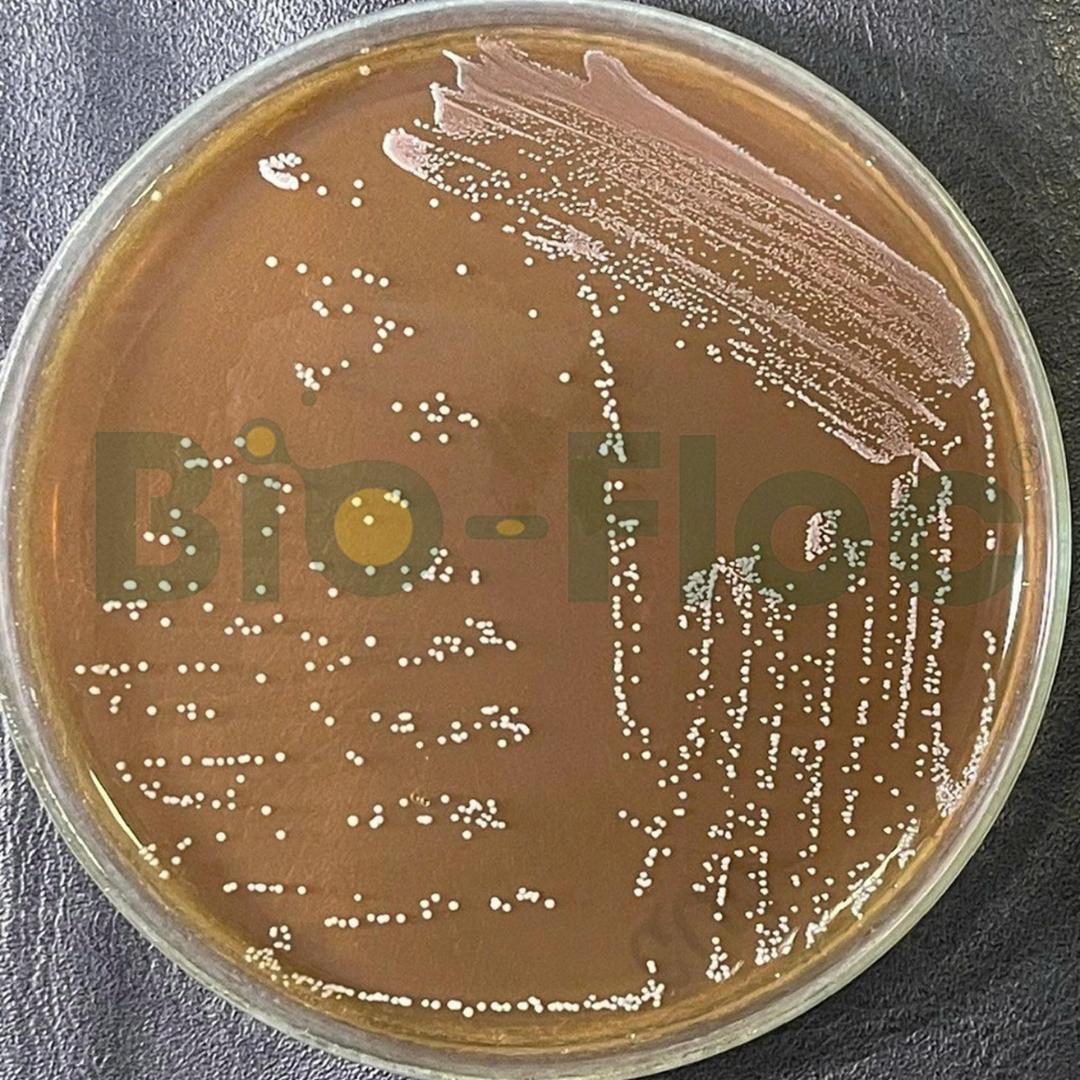
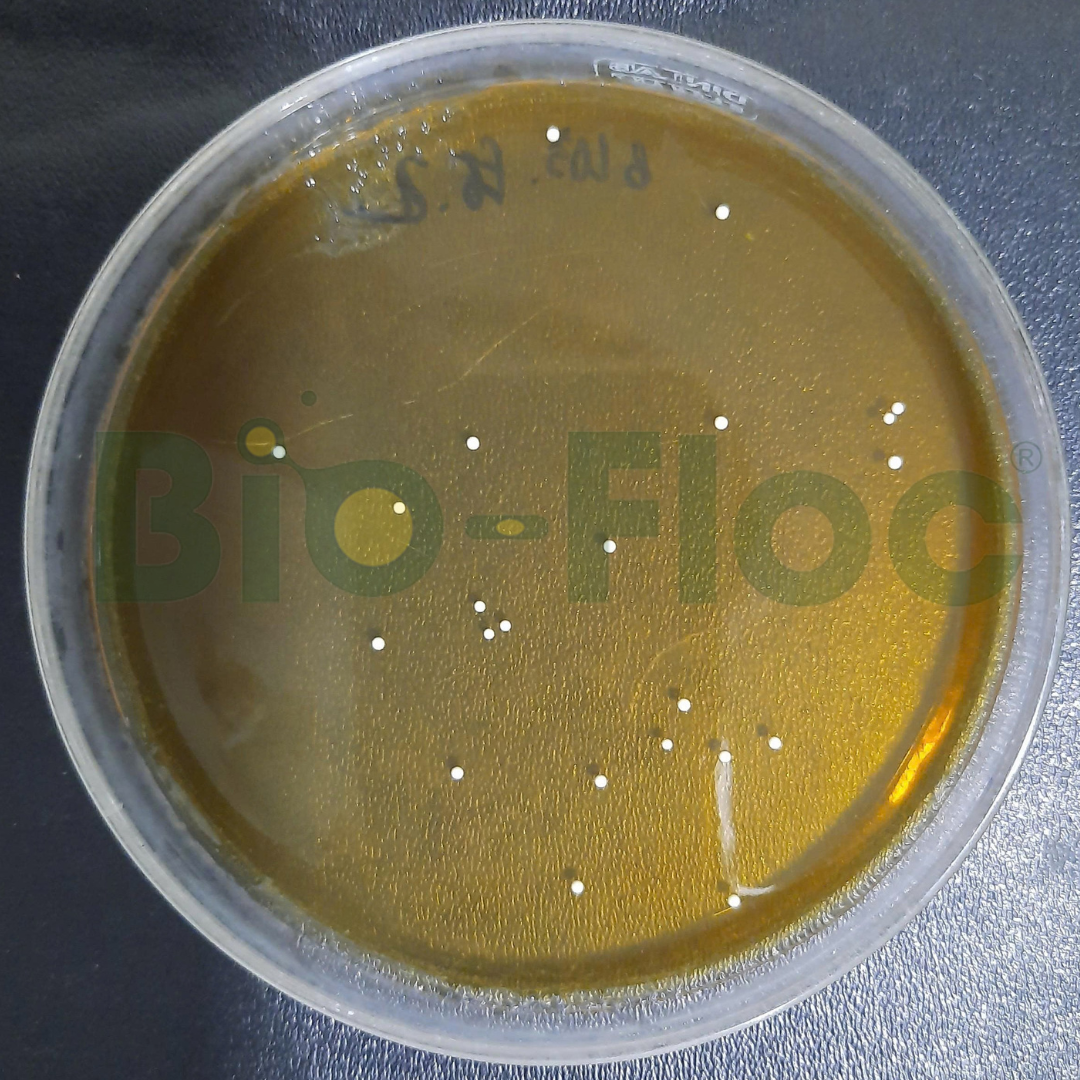
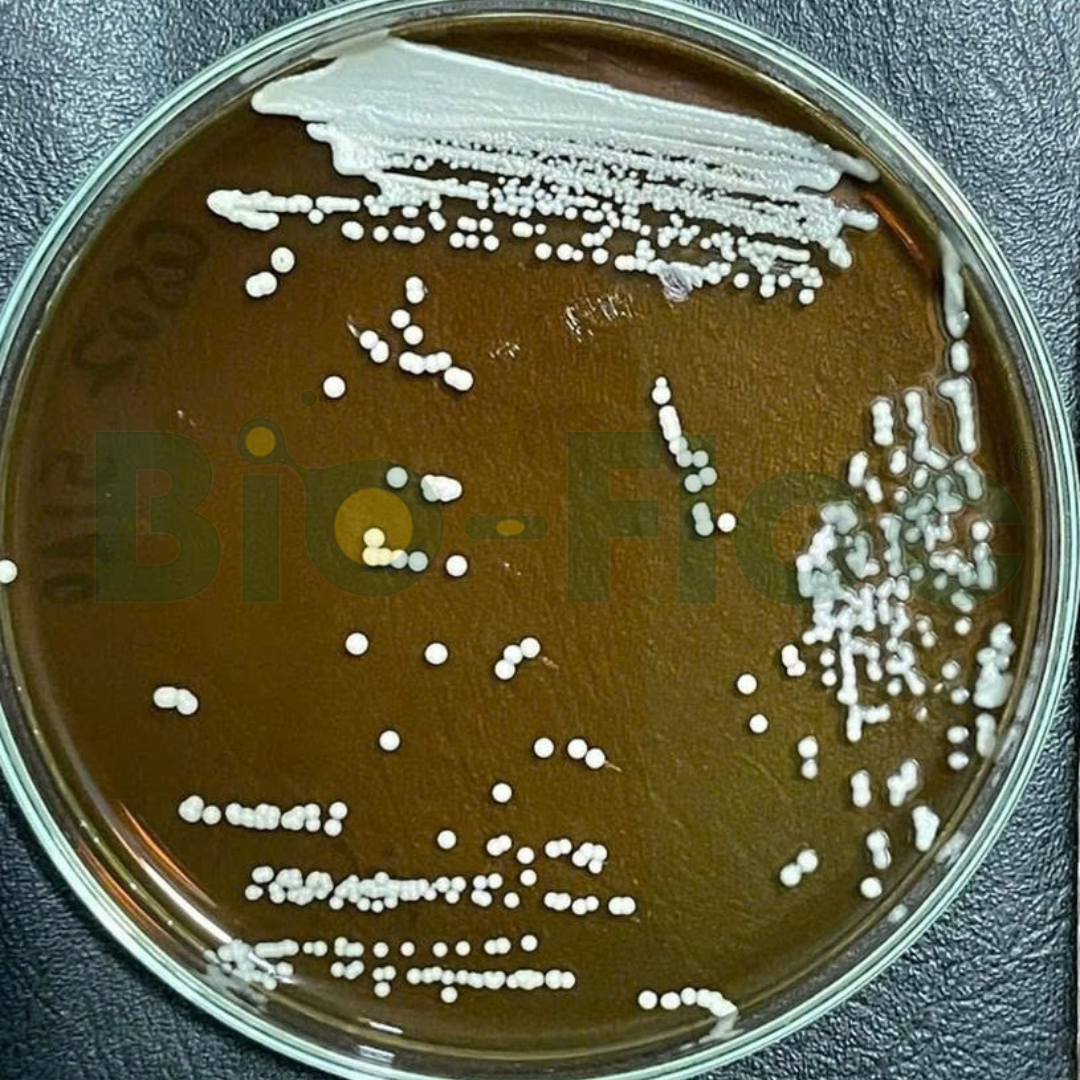
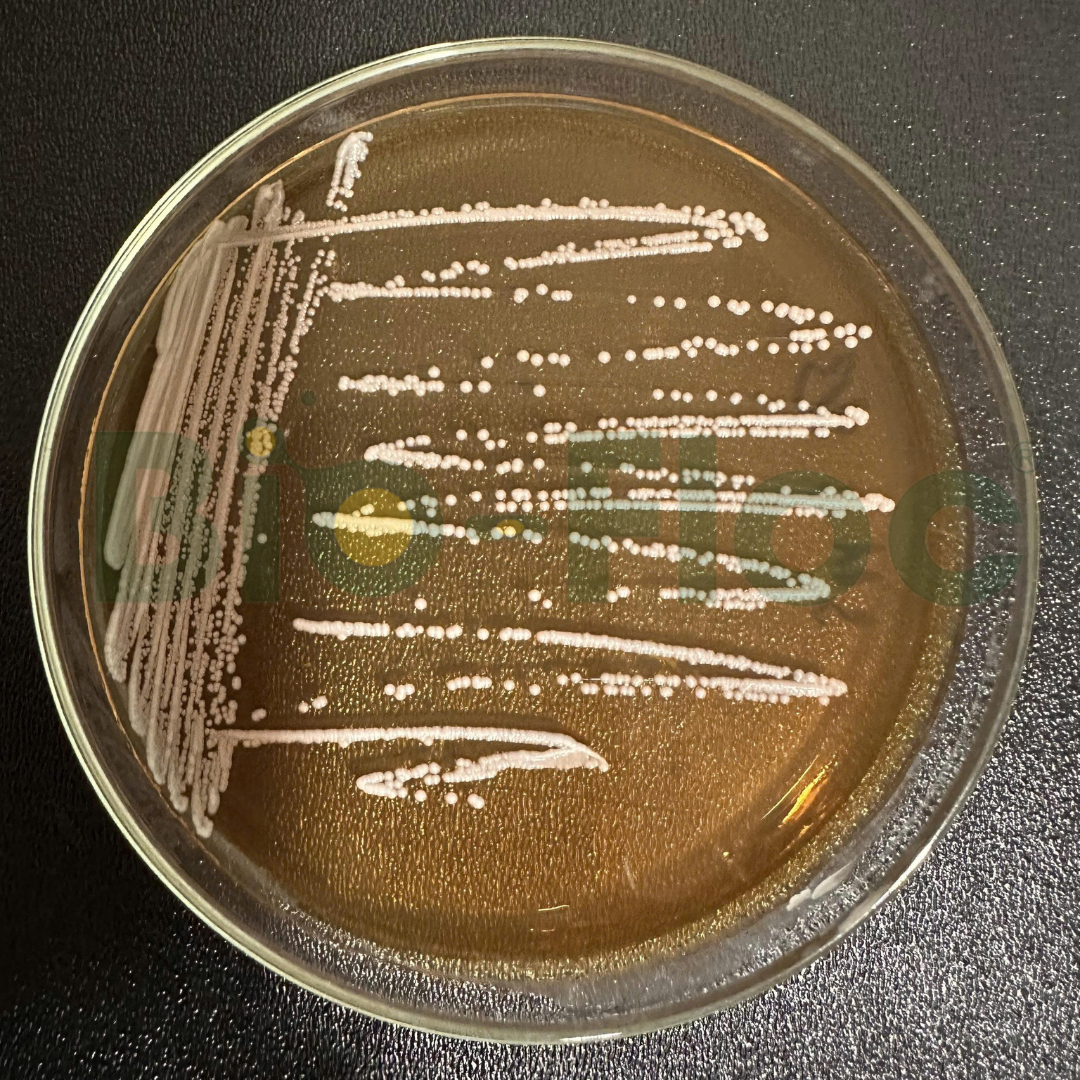
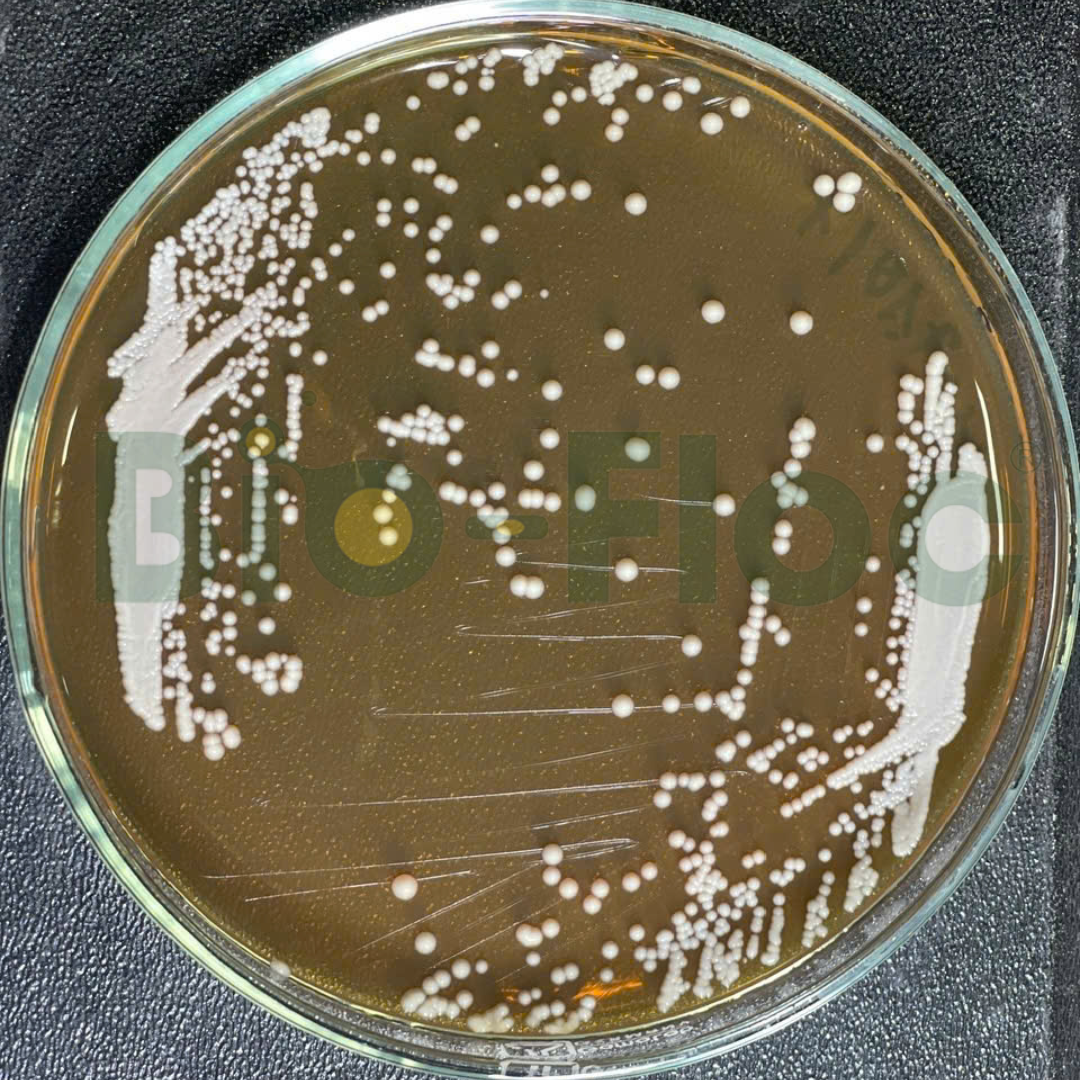
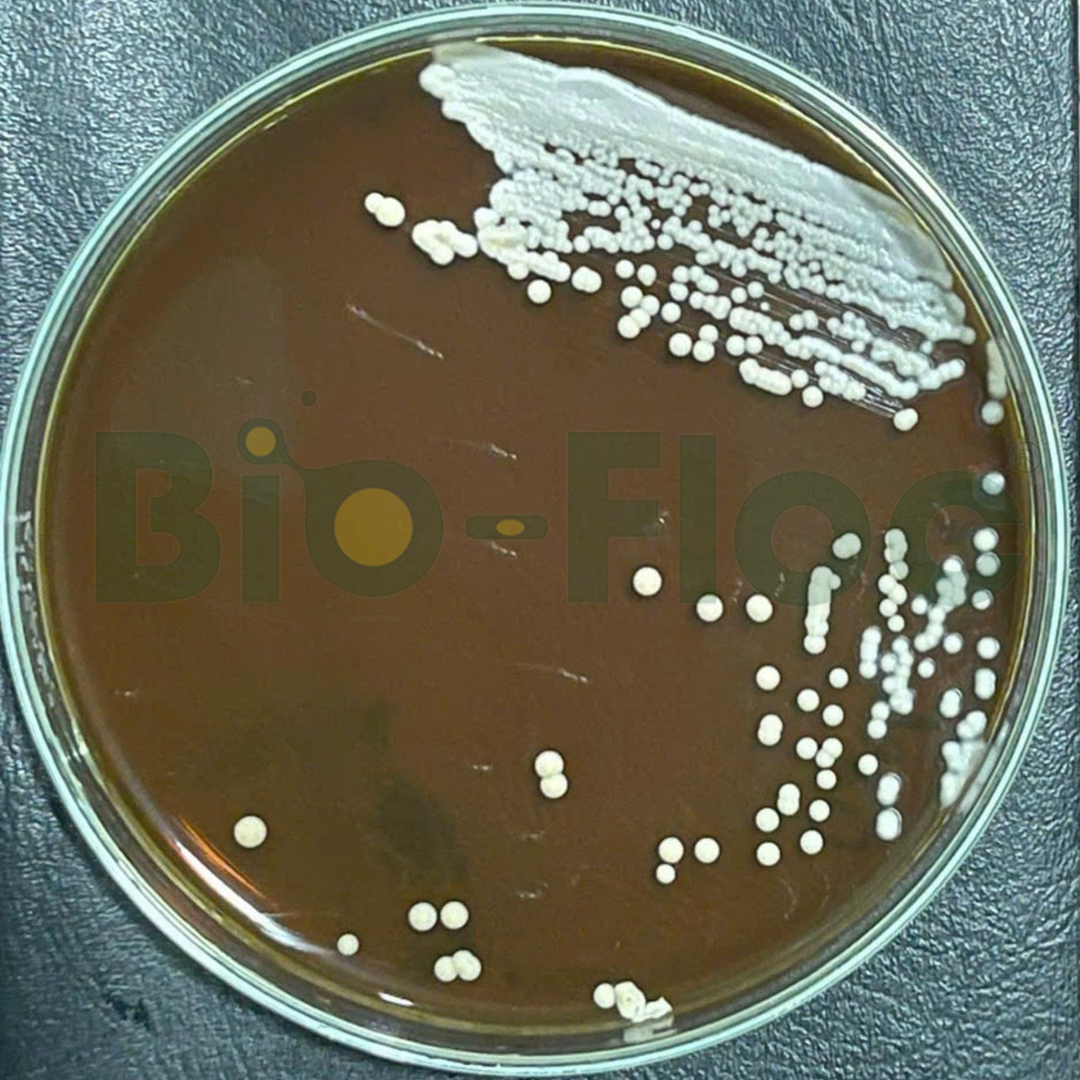

Bio-Floc tiên phong trong nghiên cứu chủng vi sinh bản địa dành riêng cho lĩnh vực thú y, giúp nâng cao miễn dịch – giảm kháng sinh – hỗ trợ tiêu hóa tự nhiên cho vật nuôi.
Liên hệ Ngay01
Nghiên cứu chuyên biệt
Tách dòng – định danh – thử nghiệm – ứng dụng từng chủng vi sinh theo từng nhóm vật nuôi: gà, heo, bò, chó mèo…
02
Bản địa hóa
Vi sinh được phân lập từ môi trường vật nuôi Việt Nam → khả năng thích nghi và hiệu quả cao hơn chủng ngoại nhập.
03
Thay thế kháng sinh
Hỗ trợ tiêu hóa, nâng miễn dịch, kháng khuẩn tự nhiên, phòng bệnh đường ruột – hô hấp – gan.
5 BƯỚC QUY TRÌNH NGHIÊN CỨU VI SINH BẢN ĐỊA
Tại Bio-Floc, mỗi dòng vi sinh bản địa đều là kết quả của một quy trình nghiên cứu nghiêm ngặt, hệ thống và ứng dụng thực tiễn cao. Chúng tôi không chỉ thu thập chủng vi sinh từ môi trường tự nhiên mà còn sàng lọc, đánh giá và phát triển dựa trên dữ liệu thực tế từ người nuôi và mô hình canh tác. Dưới đây là 5 bước cốt lõi tạo nên chất lượng vượt trội của vi sinh bản địa Bio-Floc – nền tảng cho hiệu quả bền vững trong nông nghiệp và nuôi trồng thủy sản.
01
Phân lập và làm thuần
02
Nghiên cứu đặc điểm hình thái và sinh hóa
03
Sàng lọc chủng theo mục tiêu
04
Định danh chủng giống
05
Bảo quản chủng giống -86 độ C
BỘ CHỦNG GIỐNG BẢN ĐỊA
Thư viện chủng giống bản địa – nền tảng khác biệt của Bio-Floc




Ứng dụng chính:
– Khử mùi hôi chuồng trại và đệm lót sinh học
– ‘- Canh tranh sinh học, ức chế vi khuẩn, nấm bệnh
– Cân bằng hệ vi sinh đường ruột, tăng hấp thu dinh dưỡng, kích thích miễn dịch
Đặc điểm nổi bật:
– Khả năng sinh các enzyme phân hủy chất hữu cơ: amylase, cellulase, protease
– Khả năng cạnh tranh dinh dưỡng
– Tiết ra các kháng sinh tự nhiên (bacteriocin)
– Sinh trưởng nhanh, tồn tại được ở điều kiện khắc nghiệt do có khả năng sinh bào tử

Ứng dụng chính:
– Ổn định hệ vi sinh đường ruột, hỗ trợ tiêu hóa
– Tăng cường miễn dịch tự nhiên
Đặc điểm nổi bật:
– Sinh acid lactic, ức chế vi khuẩn vi khuẩn gây bệnh đường ruột
– Sản sinh một số chất kháng sinh mạnh gồm bacteriocin, lactocidin, acidophilin…

Ứng dụng chính:
– Cải thiện tiêu hóa và hấp thu dinh dưỡng
– Ức chế vi khuẩn gây bệnh đường ruột
Đặc điểm nổi bật:
-Chứa ß-glucan, mannan oligosaccharide (MOS) giúp kích thích miễn dịch bẩm sinh ở thú y
CÔNG NGHỆ SẢN XUẤT TIÊN TIẾN
Tại Bio-Floc, vi sinh được sản xuất trên nền của 4 công nghệ cốt lõi với hệ thống quản lý chất lượng ISO 9001:2015 giúp tạo ra nguyên liệu vi sinh chất lượng cao, ổn định và phù hợp với từng điều kiện nuôi tại Việt Nam.
Là công nghệ bảo quản giống hiện đại nhất hiện nay, các chủng giống vi sinh đươc bảo quản trên thiết bị chuyên dụng ở nhiệt độ âm 80°C, đảm bảo độ ổn định chất lượng chủng giống vi sinh lâu dài.
Sinh khối vi sinh vật được cô đặc từ 30 – 50 lần bởi công nghệ lọc tiếp tuyến trước khi được làm khô giúp tăng mật độ và tế bào không bị tổn thương.
Các chủng vi sinh vật được nhân sinh khối trên hệ thống lên men tự động với các thông số kỹ thuật được cài đặt chuyên biệt cho từng chủng giống.
Công nghệ đông khô ở nhiệt độ âm 50°C và phun sấy tầng sôi giúp giữ nguyên hoạt tính sinh học của vi sinh đặc biệt với các chủng vi sinh không sinh bào tử.








